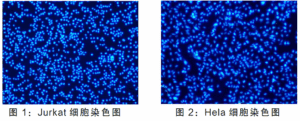

This product is a fluorescent dye based on DAPI (4′, 6-diamidino-2-phenylindole), which is widely used for DNA and nucleus staining in cellular imaging techniques. The detection principle is that DAPI binds to the minor groove in the DNA double strand and emits a strong blue fluorescence (maximum excitation and emission of Ex = 364 nm and Em = 454 nm, respectively); DAPI itself has a low fluorescence background, and the fluorescence intensity is enhanced by about 20-fold when bound to dsDNA. The product is easy to operate, only need to add DAPI Solution (Ready-to-Use) directly into the sample, after incubation for a certain period of time can be observed bright blue fluorescence, can be observed by fluorescence microscope or flow cytometry.
This product can be widely used for nuclear staining, apoptosis, cell cycle analysis of living cells, fixed cells or tissues, paraffin sections. It is a 5 μg / ml ready-to-use staining solution, no need to dilute, can be used directly, if you need to use a high concentration of DAPI staining solution, you can use the company's products. CytoDet DAPI stain (Code No. AG51013).
1. This product is a ready-to-use 5 μg / ml staining solution, easy to operate, can be added directly to the cells, without the need for dilution and other steps, the blue fluorescence can be observed after 5 ~ 20 min of staining, and the staining performance is stable.
2. DAPI binds to dsDNA with a typical blue fluorescence, which is ideal for use in cell biology experiments with green and red fluorescent groups in multicolor experiments.
| individual parts making up a compound | AG51014 | AG51016 |
| DAPI Solution (Ready-to-Use) (5 μg / ml) | 10 ml | 50 ml |
Transportation temperature: -20℃ ice bag transportation

-scaled-1-300x300.jpg)
